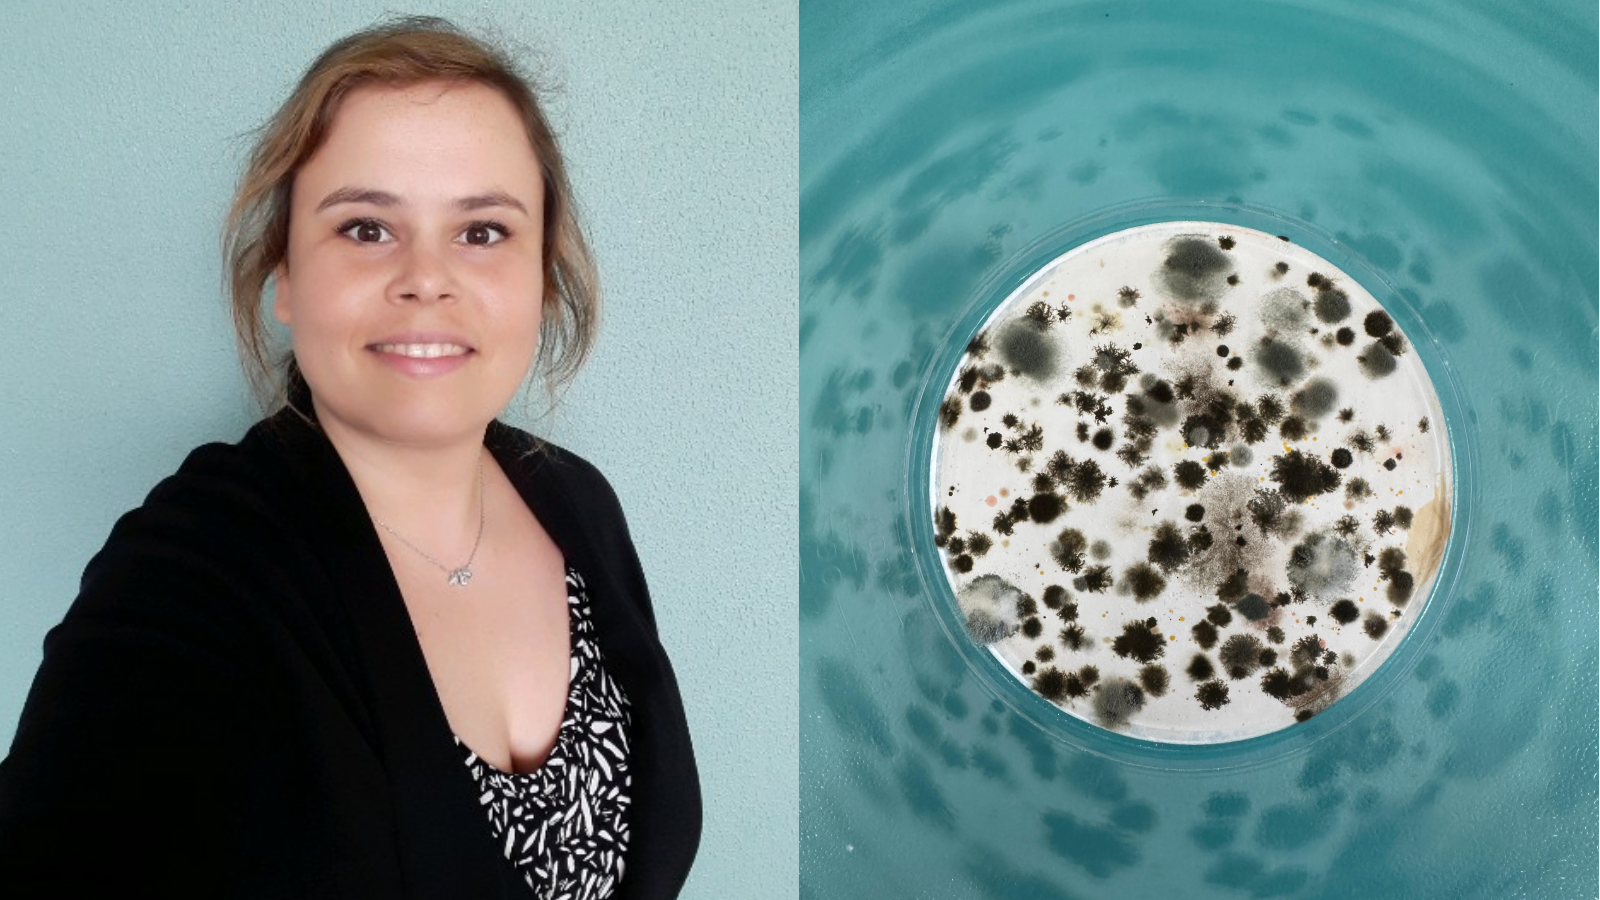

On 17 September we marked International Microorganism Day by launching a creative photo-competition open to all members of UCIBIO. The challenge: capture the fascinating world of microorganisms.
Thanks to all participants for the enthusiastic, inventive and visually striking submissions!
We invite you to watch the full video presenting all submitted photographs:
After careful deliberation the winners of this year’s competition are:
“The microbial cosmos in a filter” by Ana Margarida Dias (Biomolecular Engineering Lab)
“Urine is not sterile” by Teresa Gonçalves Ribeiro (BacT_Drugs Lab)

At UCIBIO we believe in combining scientific curiosity with visual storytelling, and this competition was a fantastic way to showcase the hidden world of microbes. Stay tuned for next-year’s edition, and thanks again to everyone who joined in celebrating microbes!
Congratulations to Ana Margarida Dias and Teresa Gonçlaves Ribeiro for their outstanding work!
Each will receive our symbolic prize, a specially-designed “I ♥ Microbiology” keychain, as a token of recognition for their creativity.
